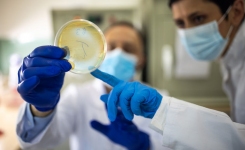
Pharmaceutical Microbiology interest Group conference report

Pharmig (Pharmaceutical Microbiology Interest Group)
Pharmig is a non-profit organisation whose main objective is to promote, support and uphold the importance and role of the pharmaceutical microbiologist as a key professional within the pharmaceutical industry, and allied industries.
Address
Stanstead Abbotts
United Kingdom